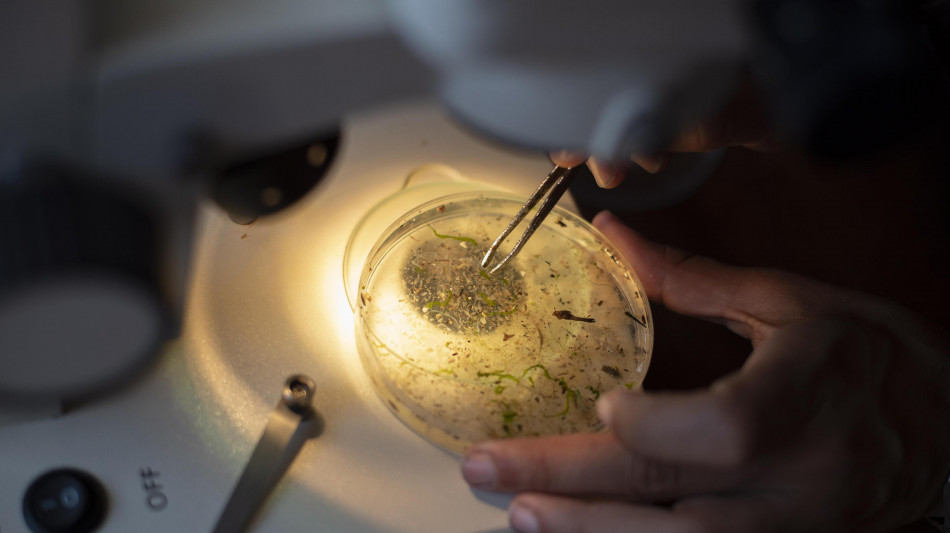
Autodistruzione cellule, scoperta causa malattia infantile Savi

Autodistruzione cellule, scoperta causa malattia infantile Savi
Alla base la proteina Sting, "sensore" del sistema immunitario
L'attivazione della proteina Sting, un sensore del sistema immunitario, è un requisito genetico e biochimico per l'innesco della morte cellulare programmata, il meccanismo che induce le cellule ad auto-distruggersi e che è anche alla base di una malattia genetica che colpisce i bambini, chiamata Savi A dimostrarlo per la prima volta è lo studio congiunto dell'Università di Colonia e dell'Ospedale pediatrico Bambino Gesù, pubblicato sulla rivista Nature. Il risultato apre nuove strade nella ricerca di terapie innovative contro le malattie autoinfiammatorie, come la Savi (vasculopatia associata a Sting con esordio infantile). Il team guidato da Gianmaria Liccardi, junior group leader presso l'Istituto di Biochimica I e affiliato al Centre for Molecular Medicine Cologne e al Cecad Cluster of Excellence for Aging Research, ha scoperto che Sting - una sorta di sensore del sistema immunitario che rileva la presenza di infezioni o danni cellulari - attiva un'altra proteina (Zbp1) responsabile di un particolare tipo di morte cellulare programmata noto come necroptosi. Una scoperta che collega la morte cellulare programmata all'origine di gravi malattie infiammatorie. I ricercatori hanno trovato, nelle cause della Savi, prove evidenti di un'attivazione anomala della morte cellulare programmata. Il blocco di questo processo in modelli animali ha alleviato i sintomi, ridotto la gravità della malattia ed esteso significativamente la sopravvivenza. "Il nostro lavoro dimostra che Sting è anche un motore diretto della morte cellulare infiammatoria", afferma Liccardi. "Colpire la morte cellulare programmata potrebbe aprire nuovi approcci terapeutici non solo per la Savi, ma anche per altre malattie autoinfiammatorie legate a Sting". I risultati aprono così la strada allo sviluppo di nuovi farmaci che inibiscono la morte cellulare programmata (la necroptosi in particolare) offrendo speranza a pazienti affetti da un'ampia gamma di sindromi autoinfiammatorie legate a Sting, attualmente incurabili.
G.Montoya--LGdM


